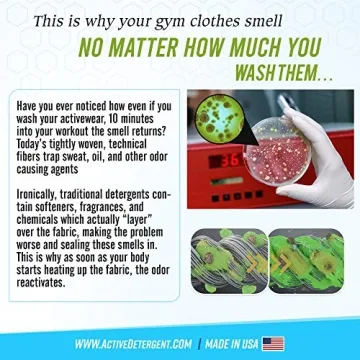
Active Wear Laundry Detergent for Sweat & Gym Clothes

Active Wear Laundry Detergent & Soak - Enzyme Booster Deodorizer
- 253
- 0
- 100+ Sold in the past week
- 💥 300+ people added this to wishlists
- ⏳ Limited quantity — order now
- ⭐️ Trusted by shoppers






 Bathroom Storage & Organization
Bathroom Storage & Organization
 Laundry Storage & Organization
Laundry Storage & Organization
 Kitchen Storage & Organization
Kitchen Storage & Organization
 Clothing & Wardrobe Storage
Clothing & Wardrobe Storage
 Storage Baskets
Storage Baskets
 Storage Bags
Storage Bags
 Air Vacuum Bags
Air Vacuum Bags
 Portable Storage
Portable Storage
 Vacuum Bag Pumps
Vacuum Bag Pumps
 Portable Shopping Carts
Portable Shopping Carts
 Storage Holders & Racks
Storage Holders & Racks
 Storage Drawers
Storage Drawers
 Storage Boxes & Bins
Storage Boxes & Bins
 Storage Bottles & Jars
Storage Bottles & Jars
 Statues, Miniatures
Statues, Miniatures
 Decorative Accessories
Decorative Accessories
 Photo Frames, Boards
Photo Frames, Boards
 Clock
Clock
 Wind Chimes, Hanging Decorations
Wind Chimes, Hanging Decorations
 Painting, Calligraphy
Painting, Calligraphy
 Flags
Flags
 Banners, Accessories
Banners, Accessories
 Music Boxes
Music Boxes
 Candles, Holders
Candles, Holders
 Door Sticker
Door Sticker
 Christian Decor
Christian Decor
 Wall Stickers
Wall Stickers
 Flower Pots
Flower Pots
 Decorative Mirrors
Decorative Mirrors
 Plates, Signs
Plates, Signs
 Bedside Lamp, Lampshade
Bedside Lamp, Lampshade
 Decorative Lamp
Decorative Lamp

Say goodbye to stubborn odors and hello to freshness with our **Active Wear Laundry Detergent & Soak**, specifically crafted for those who live an active lifestyle. This powerful powdered detergent is more than just a cleaning agent; it's your secret weapon against the relentless odors that come from sweat and intense workouts. Whether you're a dedicated athlete, a Sunday jogger, or a yoga enthusiast, our innovative formula neutralizes odors without the need for harsh chemicals or overpowering fragrances.
Made...
Show moreSay goodbye to stubborn odors and hello to freshness with our **Active Wear Laundry Detergent & Soak**, specifically crafted for those who live an active lifestyle. This powerful powdered detergent is more than just a cleaning agent; it's your secret weapon against the relentless odors that come from sweat and intense workouts. Whether you're a dedicated athlete, a Sunday jogger, or a yoga enthusiast, our innovative formula neutralizes odors without the need for harsh chemicals or overpowering fragrances.
Made in the USA and enhanced with **plant-based enzymes**, this premium detergent effectively penetrates the toughest odors that can cling to your gym and sports apparel. From workout tees and leggings to base layers, it promises to rejuvenate your activewear, keeping it fresh and clean after every wash. Each bag offers an impressive **up to 90 loads**, turning laundry day into a stress-free experience without breaking the bank.
Our formula is not only tough on odors but also gentle on fabrics and the environment. With no **SLS, phosphates, or gluten**, and being septic safe, you can trust that your laundry is being cleaned ethically and sustainably. Customers rave about the absence of synthetic fragrances, instead, their clothes emerge simply clean, allowing you to enjoy the natural scent of your gear.
Additionally, this detergent is designed to maintain the quality of your beloved activewear, ensuring longevity and performance with each use. Experience the perfect blend of effectiveness and environmental responsibility with our unique detergent that truly understands the needs of active individuals.
| manufacturer | ACTIVE |
|---|---|
| height | 10 |
| weight | 3 |
| width | 1 |
| size | 48 Ounce (Pack of 1) |
| length | 7 |
| productGroup | Drugstore |
One bag of our Active Wear Laundry Detergent can clean up to 90 loads.
Yes, our detergent is free from harsh chemicals and synthetic fragrances, making it suitable for all skin types.
While it’s specially formulated for activewear, it works effectively on regular laundry too.
Absolutely! It is free from SLS, phosphates, and gluten, and is septic safe.
No, it cleans effectively without leaving any artificial scents.
Yes, it does an excellent job at lifting dirt and stains while also combating odors.

 Giftpals.com
Giftpals.com

